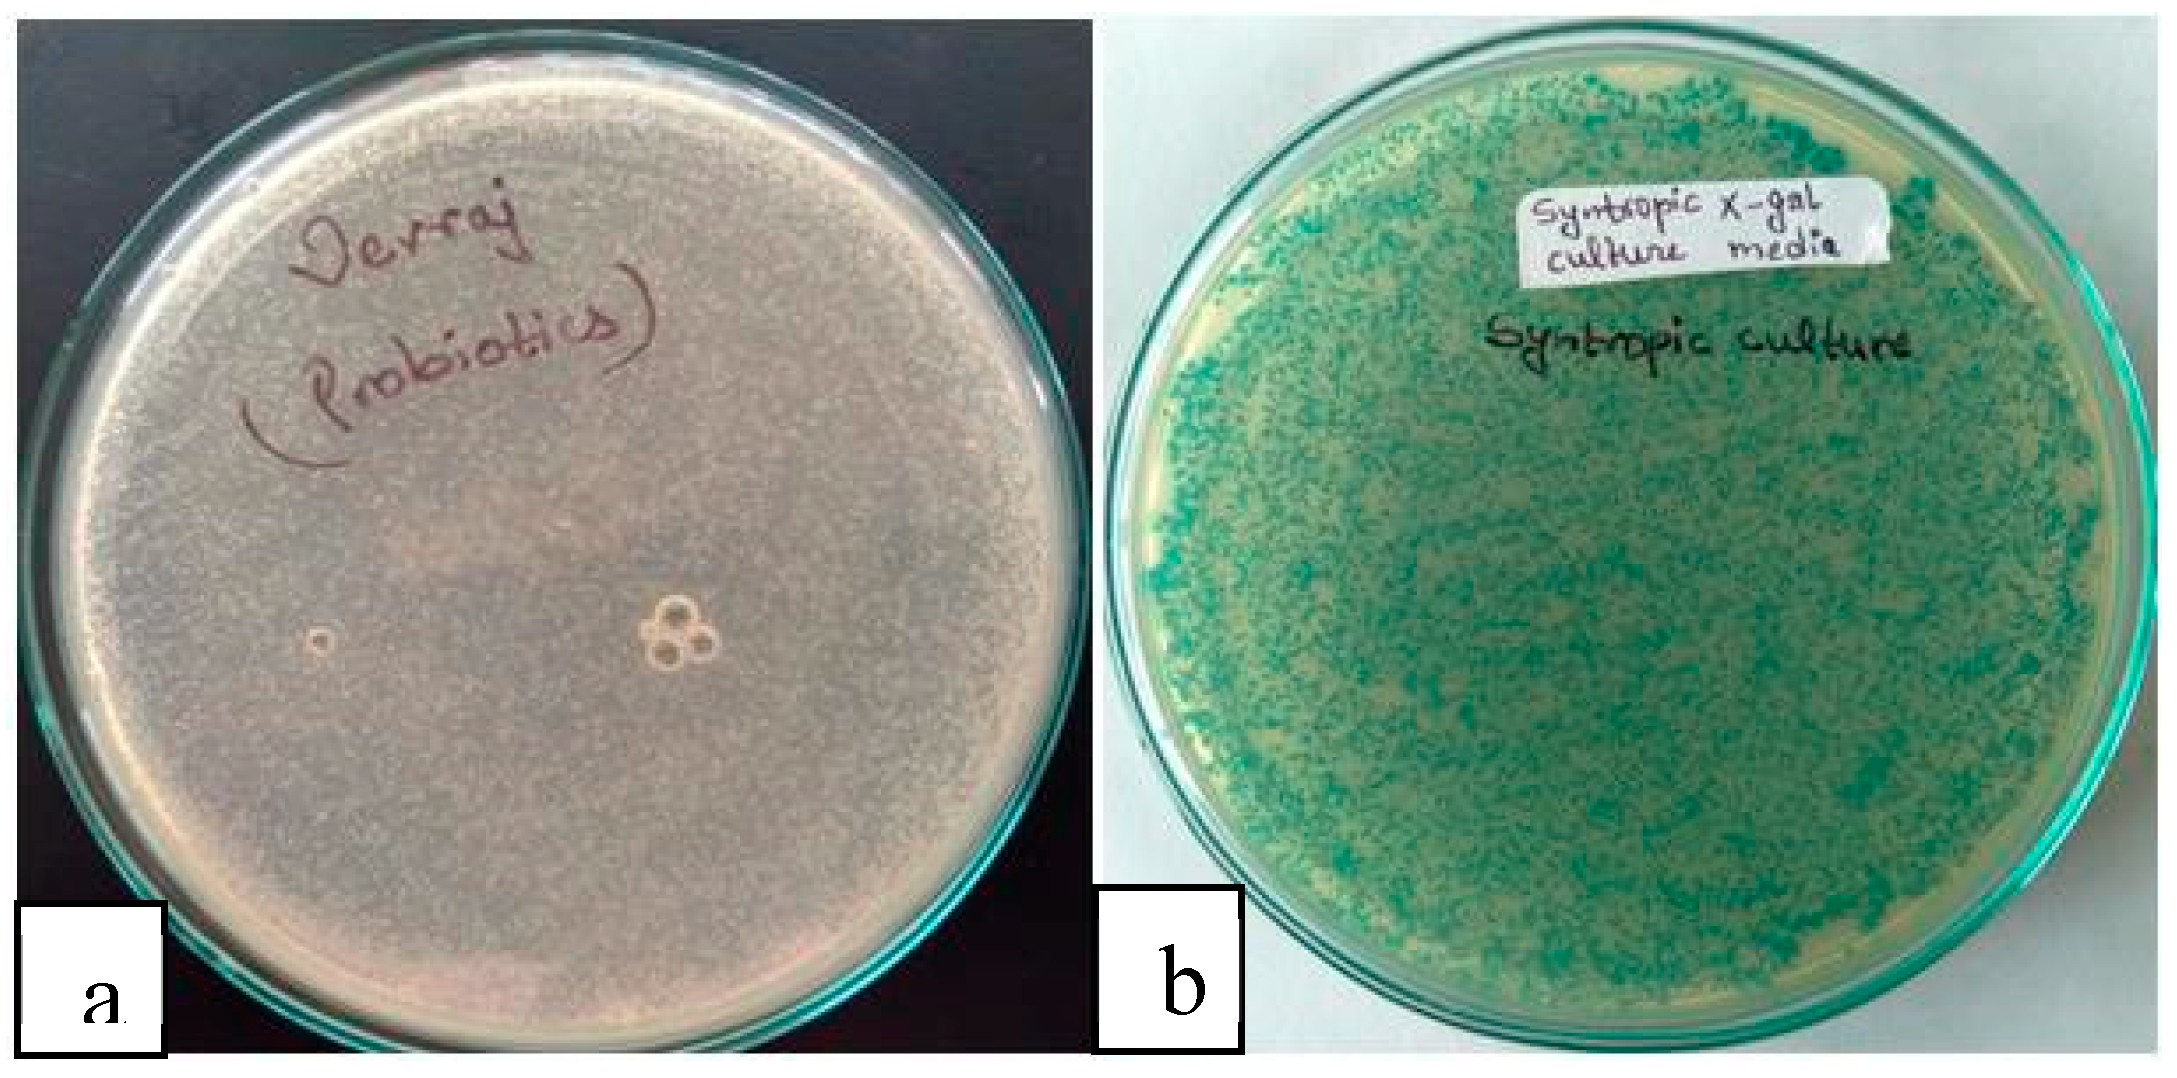
Preprints 81608 g011

Introduction
Cattle farming, as one of the oldest and most widely practiced agricultural occupations worldwide, serves as a sustainable means of milk production. The primary function of this industry is to transfer money from wealthier to impoverished communities through the production of milk, a vital source of nutrition. However, the high perishability and water content (85-90%) of raw milk present challenges in its transportation, resulting in only 8% of total raw milk being transported without undergoing processing (OECD, 2020). Cheese, a leading milk product, plays a crucial role in long-distance dairy commerce due to its superior food value and extended shelf life compared to raw milk. The production process involves coagulating milk using suitable agents such as vinegar or lemon, etc.(Wong et al., 1978). Globally, approximately 35% of raw milk is converted into cheese, making it a significant contributor to the dairy industry (Fox et al., 2017). Cheese production not only addresses the issue of surplus milk during certain seasons but also helps overcome "milk holidays" when milk procurement from farmers is interrupted. Furthermore, cheese production offers a solution to address lactose intolerance problems, as the fermentation process reduces lactose content, making it more tolerable for individuals with lactose intolerance(Leonardi et al., 2012).
However, the production of cheese results in a substantial byproduct known as cheese whey. Theoretically, for every kilogram of good cheese produced, approximately nine kilograms of whey are left over (Lappa et al., 2019). In 2020 alone, over 16 million metric tons of cheese were produced worldwide, suggesting that a significant amount of whey, approximately 9 x 16 million metric tons, was generated (Pendón et al., 2021). Whey is rich in essential nutrients, representing approximately 55% of the total milk nutrition and containing components such as lactose, soluble salts, globular proteins, trace fats, and vitamins. Lactose, which accounts for about 70% of milk lactose, contributes to the high Biological Oxygen Demand (BOD); 30,000 mg/L and Chemical Oxygen Demand (COD) ; 70,000 mg/L levels in whey (Zotta et al., 2020). The disposal of large quantities of whey poses a significant environmental challenge. It has been estimated that a small cheese factory producing 4,000 liters of whey per day (equivalent to 450 kg of cheese) would generate as much sewage as 1,900 people (Smithers, 2008). The high nutrient content of whey presents a threat to both cheesemakers and the ecosystem at large, highlighting the need for effective technology to trap and utilize its organic compounds. Various approaches are being explored for the valorization of whey lactose, with microbial fermentation being a promising route for the production of value-added products, such as bioethanol.
Fermenting lactose in whey presents several challenges. Cells must possess a Lac operon system, producing β-galactosidase and galactoside permease, to metabolize lactose effectively (Shaw et al., 2002). Only specific microorganisms, such as lactic acid bacteria (LAB) and certain wild yeast strains like Kluyveromyces lactis, K. marxianus, and Candida pseudotropicalis, have this system, but they exhibit sensitivity to ethanol concentration and have relatively low sugar conversion rates, making them less than ideal for lactose fermentation (Kosikowski & Wzorek, 1977); (Coté et al., 2004).
Saccharomyces cerevisiae, a genetically recognized as safe (GRAS) yeast species, is widely used for industrial fermentation. It has properties such as high ethanol tolerance (up to 20%), pH tolerance (up to 3.0), high yield, short generation time, and superior fermentation capacity compared to direct lactose fermenting organisms (Guimarães et al., 2010); (Maicas, 2020); (Parapouli et al., 2020). Although S. cerevisiae lacks the Lac operon system, genetic manipulation of the Lac gene or the hydrolysis of lactose into its monomers glucose and galactose, followed by fermentation by the yeast, have been explored (Guimarães et al., 2010). The enzyme β-galactosidase (E.C 3.2.1.23) is widely used in the food industry to produce lactose-free products. It breaks down the glycosidic bond of lactose, yielding glucose and galactose (Natarajan et al., 2012). β-galactosidases are produced by various organisms, including plants, bacteria, and fungi, with microorganisms, particularly bacteria, being dominant producers due to their ease of fermentation, high enzymatic activity, and stability (S. Saqib et al., 2017); (Panesar et al., 2010). It varies with organisms whether this enzyme is produced both extracellularly or intracellularly. Bacillus species have been investigated for the extracellular production of β-galactosidase, which is safe for use in the food industry (Percival et al., 2019). Lactic acid bacteria, including Bacillus and Lactobacillus species, have a good capacity for lactose metabolism and are naturally associated with yeast on different substrates, fermenting together (Natarajan et al., 2012). In such co-cultures, yeast dominates as the primary fermenter, converting reducing sugar into ethanol, while LAB produces different organoleptic organic compounds that prevent cross-contamination during fermentation (Faria-Oliveira et al., 2015). This natural association between yeast and LAB has been explored to produce bioethanol using whey as a substrate.
In addition to bioethanol, whey can also be utilized for the production of probiotic drinks. Probiotics are live microorganisms that, when consumed in adequate amounts, provide health benefits to the host (Binda et al., 2020). Lactic acid bacteria and certain yeasts, including Saccharomyces, Kluyveromyces, Bacillus megaterium, and Bacillus subtilis, have been identified as potential probiotics (Andriani et al., 2017);(Moradi et al., 2018). Probiotics have a range of benefits, including improved digestion, prevention of pathogen growth, and enhancement of bowel health and immunity (Begley et al., 2006); (McNulty & Wise, 1985) Choosing appropriate probiotic candidates is crucial, considering their viability during production, storage, and exposure to the host environment, as well as their proven health benefits. Saccharomyces cerevisiae is commonly used in the food industry to improve gut microbiota, and it has been found to enhance digestion and have potential applications in sucrase deficiency (Marteau et al., 2001); (Begley et al., 2006); (Moradi et al., 2018).
Materials and method
For sample collection and characterization, polypropylene bottles were thoroughly rinsed with 2% caustic soda and hot water to ensure cleanliness. Freshly prepared whey samples were then collected from 10 different cheese producers in Birgunj. To remove any impurities, the whey samples were filtered through muslin cloth and subjected to pasteurization in the laboratory. Following pasteurization, the whey samples were stored in a refrigerator at -4°C until further use. Microbiological analysis was conducted to determine the microbiome profiles of the whey samples. Additionally, various parameters including pH, lactose content, protein content, phosphate, calcium, vitamin content, and biological oxygen demand were studied using established methods cited in relevant literature sources (A. Saqib & Whitney, 2011); (Helm et al., 2012; Waterborg, 2009).
The isolation and validation of organisms involved the collection of soil samples from five different areas in the Panchase region of the Pokhara valley. Bacterial strains Bacillus subtilis and Bacillus megaterium were isolated and characterized. One gram of each soil sample was enriched in 5 ml of sodium acetate base media and subjected to heat treatment at 80°C for 10 minutes to eliminate vegetative cells. Pour plating techniques were employed using acetate agar media, and the plates were then incubated at 28°C for 48 hours. Subsequently, fast-growing large colonies of B. megaterium were transferred to L-tryptophan and phenol agar media for further screening. Chalky colonies indicative of presumptive B. subtilis were transferred to agar media containing malic acid, catechol, and phenol. Surviving colonies on these selective media were further characterized through morphological, biochemical, and molecular methods to validate putative Bacillus strains. Additionally, Lactobacillus (LB) and Saccharomyces cerevisiae (SC) strains were procured in activated dried powdered form and revived in MRS (De Man, Rogosa, and Sharpe) and SD (Sabouraud dextrose) broth, respectively.
To validate the lactose-metabolizing nature of the Bacillus strains, the NA X-gall method was employed. This method assessed the ability of the bacterial strains to metabolize lactose. Furthermore, the β-galactosidase enzyme activity was determined using the ONPG test method, which followed the procedures described by Percival et al., 2019.
Figure 1.
Graphical representation of valorization of whey with co-culture of yeast and LAB.
Figure 1.
Graphical representation of valorization of whey with co-culture of yeast and LAB.
For whey fermentation, a 2-liter fermentation batch was prepared using whey as the substrate in a fermenter equipped with an airlock and thermometer. The initial pH was adjusted to 6.5 by adding sodium carbonate, and the mixture was subsequently autoclaved. An overnight bacterial culture comprising strains S13, S24, and LB, with an inoculum size of 1-2% relative to the batch size, was aseptically inoculated into the fermenter. The fermentation process took place at room temperature (28 ± 2°C) for a duration of 24 hours. Simultaneously, a yeast inoculum of 200 ml was prepared in Sabouraud dextrose broth (SDB) using an overnight culture of Saccharomyces cerevisiae. On the following day, the yeast inoculum and yeast nutrients were aseptically transferred to the fermenter to facilitate fermentation under optimal conditions. The pH change, lactose concentration, and ethanol concentration were monitored and measured at the end of the fermentation period, utilizing methods described by Seo et al., 2009. After fermentation, ethanol distillation was then performed using both traditional and revised methods. The revised method involved employing a rotary evaporator under vacuum pressure to bypass the high heating step of conventional distillation procedures. SDB using an overnight culture of S. cerevisiae. On the following day, the yeast inoculum and yeast nutrients were transferred aseptically to the fermenter and left to ferment under optimal conditions.
The pH change, lactose concentration, and ethanol concentration were examined as explained in Seo et al., 2009 at the end of the fermentation. Ethanol distillation was carried using both traditional and revised methods. Experiments were designed to bypass the high heating step of conventional distillation procedures by using a rotary evaporator in which vacuum pressure plays a major role in ethanol distillation from the fermentation broth. Moreover, the remaining broth after ethanol distillation was subjected to a viability test using the pour-plate method in a specific medium. This test aimed to determine the presence and viability of the fermenting organisms in the remaining broth.
For probiotic criterion tests, several in-vitro assessments were conducted to evaluate the presumptive probiotic strength of the organisms used in fermentation. Temperature, pH, bile, and gastric juice tolerance tests were performed to determine the organisms' ability to withstand and survive under simulated gastrointestinal conditions. Following these tests, the fermentation broth that remained after ethanol distillation was placed in a stability chamber at both room temperature (RT) and relative room humidity (RH) for a duration of one month. After the incubation period, a cell viability test was conducted using the pour-plate method with a 100-fold dilution to assess the survival and viability of the organisms in the broth. To examine the potential cross-contamination with pathogens, a pathogenic test was carried out using WHO prioritized strains, including Pseudomonas aeruginosa, Staphylococcus aureus, Escherichia coli, Salmonella, and Shigella. The testing procedure followed the guidelines outlined in the Indian Pharmacopeia (IP) to ensure the rigorous assessment of potential pathogenic contamination.
Results and Discussion
The whey sample collection and characterization revealed important insights regarding the current practices and composition of whey in the cheese manufacturing industry. Field observations indicated a lack of awareness among cheese manufacturers regarding the nutritional value of whey and the absence of effective utilization strategies. It was commonly observed that whey was considered a valueless byproduct and disposed of untreated. The whey samples were subjected to detailed analysis, and the average results are summarized in the table below.
Table 1.
Composition of the whey samples analyzed.
Table 1.
Composition of the whey samples analyzed.
| Components |
Composition in whey |
| Color |
White or golden yellow |
| pH |
4.5 |
| Total solid |
55g/L |
| Total protein |
9.8g/L |
| Lactose |
41g/L |
| Soluble phosphate |
45.9 µg/L |
| Soluble calcium |
0.39g/L |
| Vitamin B2
|
0.0016 mg/L |
| Vitamin B6
|
0.0098 mg/L |
| BOD |
5500 mg/L |
| Total calorific value |
32 Kcal/L |
The findings indicated that approximately 70-80% of the milk volume is eluted as whey during cheese production. The major organic compound present in whey was lactose, accounting for around 4.1% of the composition. Protein content was found to be approximately 0.98%, with trace amounts of phosphate, calcium, and vitamins also present. These composition findings were consistent with previous studies, such as the work conducted by (Papademas & Kotsaki, 2020). The pH of the whey samples ranged from 3.5 to 7.3, which was influenced by the source of milk and the type of cheese coagulation methods employed. This variation in pH is well-documented in the research conducted by (Luongo et al., 2019). Biological oxygen demand (BOD) analysis revealed that the whey samples required 5500 mg/L of oxygen for breakdown, which was significantly lower than the values reported in the review by (Macwan et al., 2016). This discrepancy may be attributed to in-process errors or sample variations.
Considering the current global dependence on non-renewable petroleum-based energy sources and their detrimental impact on climate change, researchers are actively exploring alternative substrates for the production of green energy, such as bio-ethanol. However, the use of grains and sugarcane, which are primarily cultivated for food markets, as fermentation substrates for bio-ethanol production remains a topic of debate. Therefore, whey lactose emerges as a potential alternative substrate for bio-ethanol production due to its abundance, low cost, easy availability, and the presence of essential minerals and vitamins necessary for microbial manipulation. This utilization of whey lactose as a renewable and sustainable source of energy aligns with the global efforts to reduce reliance on fossil fuels, as highlighted by (Licht, 2003) and (Fang et al., 2010).
Organisms Isolation and validation
Bacillus megaterium
During the isolation process of Bacillus strains, it was necessary to eliminate vegetative cells as Bacillus strains are known to be spore-forming and thermostable (Scholle et al., 2003). To achieve this, the samples were heated, which facilitated the removal of vegetative cells while the spores remained intact. These strains possess the ability to form endospores under harsh conditions and are capable of metabolizing acetate carbon ((Williams et al., 2012)). Consequently, larger and fast-growing colonies were selected from the acetate plates for further screening.
Figure 2.
Bacterial colonies on a) Sodium acetate, b) Tryptophan and c) Phenol agar media.
Figure 2.
Bacterial colonies on a) Sodium acetate, b) Tryptophan and c) Phenol agar media.
In the provided image, the colonies exhibited viability on tryptophan and phenol media, indicating that they were putative Bacillus megaterium strains. This finding aligns with the previous work conducted by(Bouknight & Sadoff, 1975) and by (Briggs, 1966), further supporting the identification of these colonies as Bacillus megaterium strains. Out of the 33 isolates initially screened from five different soil samples, microscopic analysis, Gram staining and subsequent biochemical studies revealed that only nine isolates exhibited Gram-positive characteristics and rod-shaped morphology, positive reactions for catalase and citrate utilization, while indole production was negative. These positive biochemical characteristics narrowed down the selection to nine isolates, which were then subjected to further molecular tests.
To conduct molecular characterization of the putative Bacillus megaterium strains, genomic DNA (gDNA) was extracted from the isolates. PCR amplification was performed using universal primers targeting the 16s rRNA genomic region. Gel electrophoresis of the PCR products revealed similar band sizes in five samples, while a 100 bp ladder was used as a size reference. The amplified product exhibited a size of 1500 bp, confirming the presence of bacteria and suggesting that these isolates were indeed putative Bacillus megaterium strains. This molecular characterization provided additional evidence to support the identification of these isolates as Bacillus megaterium strains and laid the foundation for further investigations and analysis in the study.
Figure 3.
PCR amplification of Bacillus megaterium genomic DNA by universal 16s rRNA primer. Ladder used is of GeneRulerTm 100 bp which is supplied with 6X loading Dye on 1% agarose gel electrophoresis.
Figure 3.
PCR amplification of Bacillus megaterium genomic DNA by universal 16s rRNA primer. Ladder used is of GeneRulerTm 100 bp which is supplied with 6X loading Dye on 1% agarose gel electrophoresis.
The PCR product of the isolates were further characterized by DNA sequence analysis to confirm the bacterial species. The sequence read obtained showed maximum resemblance with the presumed respective bacteria. The sample S13 showed 95% with the gene cluster sequence of Bacillus megaterium available from gene bank database. The chromatogram obtained from sequencing are shown in the figure below.
Figure 4.
Chromatogram of sample S13 (a) for forward primer sequence (b) for reverse primer sequence.
Figure 4.
Chromatogram of sample S13 (a) for forward primer sequence (b) for reverse primer sequence.
The sequence obtained by DNA sequencing was further characterized by multiple sequence alignment. The highly similar sequence obtained in BLAST search indicate a significant alignment of the putative DNA sequence to 16s rRNA genes of Bacillus megaterium. The cluster approach called neighbor joining (NJ) method was used for the reconstruction of phylogenetic trees that yielded unrooted tree with branch lengths as follows:
Figure 5.
16s rRNA sequence tree generated with the neighbor joining method with 1000 bootstrap resampling for Bacillus megaterium (S13).
Figure 5.
16s rRNA sequence tree generated with the neighbor joining method with 1000 bootstrap resampling for Bacillus megaterium (S13).
According to the 16s rRNA phylogenetic tree, S13 has a close relationship with Bacillus megaterium. The tree shows that the 16s rRNA sequence of this organism is very similar to Bacillus megaterium16s rRNA sequences. The bootstrap results in common interprets the probability that phylogenetic estimation represents the true phylogeny. Explicitly, under various conditions such as equal rates of change, symmetric phylogenies, and internodal change of <20% of the characters, bootstrap proportions of >70% usually correspond to a probability of >95% that the corresponding clade is real. Therefore, S13 showed the identical similarities with Bacillus megaterium.
Upon examination of the nutrient agar media, chalky colonies were observed, indicating the presence of certain isolates. Out of the 50 randomly picked colonies from the agar, only 30 isolates were able to grow on the maleic acid media. These isolates were then cultured in media containing catechol as a reduced carbon source. Among these, only the isolates that demonstrated survival in phenol-containing media were presumed to be Bacillus subtilis strains, consistent with the findings reported by (Bouknight & Sadoff, 1975) and (Briggs, 1966).
Figure 6.
Colonies of bacteria on a) NA, b) Maleic acid agar, c) catechol, and d) phenol agar plate.
Figure 6.
Colonies of bacteria on a) NA, b) Maleic acid agar, c) catechol, and d) phenol agar plate.
Gram's staining was performed on the 30 isolates, and it was found that only 17 isolates displayed Gram's positive staining and rod-shaped morphology. The remaining 13 isolates were discarded since Bacillus subtilis is known to exhibit these characteristics (Borriss et al., 2018). This observation suggested the presence of spore-forming organisms that could utilize maleic acid as a sole carbon source and support their growth. Bacillus subtilis, known for its rod-shaped morphology, Gram's positive staining, and spore-forming ability, typically gives positive results for catalase and citrate tests, and negative results for indole and MR tests. Although there was a difference observed in the citrate reduction test, the similarities in other characteristics led to the identification of these isolates as putative Bacillus subtilis strains.
The putative Bacillus subtilis isolates were subjected to molecular characterization. Genomic DNA (gDNA) was extracted from the Gram-positive stained bacteria, and PCR amplification was performed using universal primers targeting the 16S rRNA genomic region. The amplified products, with a size of 1500 bp, confirmed the presence of bacterial DNA in the isolates and supported their identification as putative Bacillus subtilis strains.
Figure 7.
PCR amplification of Bacillus subtilis by 16s rRNA universal primer. Ladder used is of GeneRulerTm 100 bp which is supplied with 6X loading Dye.
Figure 7.
PCR amplification of Bacillus subtilis by 16s rRNA universal primer. Ladder used is of GeneRulerTm 100 bp which is supplied with 6X loading Dye.
Furthermore, the obtained DNA sequences were analyzed through multiple sequence alignments and compared to known sequences in the BLAST database. The results of the BLAST search revealed a significant alignment between the putative DNA sequence and the 16S rRNA genes of Bacillus subtilis, further supporting their identification. Phylogenetic trees were constructed using the neighbor-joining (NJ) method, which showed the evolutionary relationships among the putative Bacillus subtilis strains and other related organisms.
Figure 8.
16s rRNA sequence tree generated with the neighbor joining method with 1000 bootstrap resampling for Bacillus subtilis 24.
Figure 8.
16s rRNA sequence tree generated with the neighbor joining method with 1000 bootstrap resampling for Bacillus subtilis 24.
In the 16S rRNA phylogenetic tree, strain S24 showed a close relationship with Bacillus subtilis, indicating a high similarity between their 16S rRNA sequences. The bootstrap analysis supported the reliability of the phylogenetic estimation, with high bootstrap proportions indicating a high probability of the corresponding clades representing the true phylogeny. Based on this analysis, strains S13 (Bacillus megaterium) and S24 (Bacillus subtilis) were selected for further studies.
The selection of these bacterial strains was based on their initial potential as probiotics and their ability to utilize lactose as a carbon source. Additionally, yeast strains were selected for their ability to ferment sugar and produce bio-ethanol, while also possessing probiotic capabilities. Previous studies, such as the one conducted by (Natarajan et al., 2012), have demonstrated the lactase synthesizing ability of Bacillus species, making them suitable for lactose sugar hydrolysis.
Blue colonies of strains S13 and S24 were observed on the nutrient agar plates infused with X-gal which indicates the presence of the hydrolyzing enzyme β-galactosidase. Nutrient agar medium supplemented with X-Gal, a chromogenic substrate, was used for confirming the β-galactosidase producing organisms (Kamel et al., 2016). However, colonies of yeast SC was observed white in color which resembled with the color of control that indicates the absent of lac operon in their cells.
Figure 9.
Blue colonies of bacteria on NA plates infused with X-Gal.
Figure 9.
Blue colonies of bacteria on NA plates infused with X-Gal.
To investigate the growth behavior of the selected bacterial strains in whey, a medium with whey as the sole carbon substrate was prepared. The optical density (OD) of the cultures was measured at 600nm at 24-hour intervals and the data was plotted on a graph. The results revealed that all three bacterial strains exhibited healthy growth in the whey medium.
Among the three strains, LB showed the maximum growth in the whey medium. This observation could be attributed to the adaptation of LB to dairy products, as it is commonly found in such environments. On the other hand, strains S13 and S24 are soil-borne bacteria, and their ability to metabolize lactose in the whey medium requires further investigation and study. Interestingly, when all three bacterial strains were combined in a consortium, their growth pattern was significantly higher compared to the individual organisms. This suggests that the interaction and synergistic effects between the strains may have contributed to the enhanced growth in the whey medium.
The growth data obtained from the OD measurements and plotted graph provide valuable insights into the growth dynamics of the bacterial strains in the whey medium. Further investigations and detailed studies are required to explore the lactose-metabolizing capabilities of strains S13 and S24, as well as to understand the specific mechanisms behind the observed growth patterns in the consortium
Figure 10.
Curve showing growth of organisms in whey broth, lactose as sole available carbon source.
Figure 10.
Curve showing growth of organisms in whey broth, lactose as sole available carbon source.
Following the completion of fermentation, a quantitative analysis of the fermentation broth was conducted. The summary of whey wine fermentation was given in the table.
Table 2.
Summary of whey fermentation.
Table 2.
Summary of whey fermentation.
S.N. |
Parameter |
Result |
| Before (Whey) |
After (Whey wine) |
| 1. |
°Brix |
5.5 |
1.6 |
| 2. |
Color |
Clear yellowish |
Turbid white |
| 3. |
pH |
3.8 |
3.5 |
| 4. |
Lactose |
41g/L |
12g/L |
| 5. |
Ethanol |
- |
9.2g/L |
| 6. |
Ethanol yield |
- |
0.23g/L |
| 7. |
BOD |
5500 mg O2 per liter |
1200 mg O2 per liter |
The ethanol concentration in the whey wine samples was determined using the method described in (Seo et al., 2009b), revealing an ethanol concentration of approximately 0.92% with a sugar conversion rate of 72%. It is worth noting that this ethanol concentration is relatively low compared to other whey fermentation studies. For instance, (Teixeira & Domingues, 2010) reported an ethanol concentration of 7.4% using a genetically engineered strain of Saccharomyces cerevisiae. The lower ethanol concentration observed in this study may be attributed to factors such as the relatively low lactose concentration, competition for substrate among different organisms, and the slow rate of fermentation.
Despite the lower ethanol concentration achieved, it is worth considering the potential impact on the world fuel market. The 72% yield obtained in this study suggests that, in the year 2020 alone, around 5 million tons of ethanol could have been produced worldwide if the entire lactose production was converted (Pendón et al., 2021). This represents a significant contribution towards addressing the global energy crisis and the search for alternative fuels to replace fossil fuels.
Additionally, the calculation of the biochemical oxygen demand (BOD) of the fermentation broth indicated a reduction in the organic molecule load of approximately 80%. This reduction can be attributed to the microbial activities involved in converting lactose into simpler molecules. Consequently, this fermentation method offers potential environmental benefits by alleviating the issues associated with whey management and reducing the environmental impact.
While the observed ethanol concentration may not make whey lactose an optimal choice as a fermentation substrate for bio-ethanol production compared to recognized substrates like sugarcane and cornstarch, or emerging second-generation technologies utilizing lingo-cellulosic biomass (Guimarães et al., 2010), it is important to consider the advantages of utilizing whey as a waste effluent. Whey represents a significant volume of waste, providing a distinct advantage over food feedstock such as corn for ethanol production. Furthermore, feedstock costs constitute a major portion of overall biofuel production costs, with two-thirds of ethanol production costs attributed solely to the substrate (Claassen et al., 1999). The exploitation of whey lactose as a fermentation substrate could potentially alleviate the growing conflict between food and fuel production, particularly in light of the projected increase in global food demand. According to a report by the World Bank, the world will need 70 to 100% more food by 2050 due to population growth (Mondiale, 2008). Therefore, utilizing whey lactose as a substrate offers a promising solution to this conflict. Additionally, unlike fossil fuels that take millions of years to form, whey can be generated sustainably within a relatively short period alongside cheese production. Furthermore, the abundant availability of bio-waste is not only characterized by quantity but also by renewability, which are significant advantages over fossil fuels. Moreover, milk production resources are more evenly distributed geographically compared to fossil fuel reserves.
Following the analysis of the whey wine, ethanol was distilled from the fermentation broth using different temperature conditions. The results and conditions of the distillation process are summarized in the table below.
Table 3.
Summery of alcohol distillation.
Table 3.
Summery of alcohol distillation.
| S.N. |
Parameters |
Distillation conditions / results |
| Conventional (applying high heat) |
Vacuum rotary evaporator |
| 1. |
Temperature (°C) |
62-65 |
28-30 |
| 2. |
Vacuum |
- |
applied |
| 3. |
Time consumed (for 1 liter mead) |
20-25 minutes |
More than 2 hrs. |
| 4. |
Condition of whey wine |
More dark yellow |
No change |
| 5. |
Cells viability |
Nil |
Viable |
It was observed that ethanol could be successfully distilled at various temperatures, with the fermentation broth remaining clear in color and the viability of the organisms unaffected when distillation was performed at room temperature. However, at higher temperatures, a dark coloration of the broth was observed. This discoloration may be attributed to reactions between residual sugars present in the broth and nitrogen compounds, which can lead to damage and make the management of the spent wash challenging (Somoza, 2005). Additionally, it is important to note that as the ethanol concentration in the broth decreases, the rate of energy consumption during distillation increases, which is a drawback of conventional distillation processes used in microbial ethanol production, such as whey wine distillation (Ladisch & Dyck, 1979). To overcome these challenges, alternative methods were explored. Vacuum distillation, although time-consuming, was found to preserve the natural aroma of the substrate in ethanol, as well as in the spent leftover, which can be vital in certain fermentations, such as mead fermentation (Iglesias et al., 2014). (Kumar et al., 2010) also employed vacuum distillation for ethanol dehydration and found that at higher pressures, thermal decomposition occurred. However, at low pressure, such as under a vacuum, ethanol did not form an azeotrope with the components in the broth and could be theoretically separated (Black & Ditsler, 1972).
After the ethanol distillation process, a viability test of the organisms was conducted. Viable cells were only found in the fermentation broth that underwent distillation at room temperature using a vacuum. In this work, distillation was performed to achieve the lowest possible concentration of ethanol, resulting in an ethanol-free fermented broth containing probiotic organisms that were utilized in the fermentation process. These findings suggest that distillation at room temperature using a vacuum is a suitable method for ethanol removal, as it preserves the viability of the probiotic organisms present in the fermented broth. This ethanol-free fermented broth can potentially be utilized for various applications where the presence of probiotic organisms is desired.
Probiotic tests
To further investigate the potential probiotic nature of the presumptive strains, in-vitro tolerance tests were conducted in the laboratory. The strains demonstrated viability and tolerance to bile salts, gastric juice, temperatures up to 42°C, and pH levels as low as 1.5. The details of these tests are summarized in the table.
Table 4.
summary of in-vitro probiotic tests.
Table 4.
summary of in-vitro probiotic tests.
| Organisms |
Parameters |
Temperature
(20-42°C) |
pH (6.0 -1.5) |
Salt
(Oxgall 5%) |
Gastric juice |
| S13 |
+++ |
+ |
++ |
+ |
| S24 |
++ |
+ |
++ |
+ |
| LB |
++ |
++ |
++ |
+ |
| SC |
+++ |
+++ |
+++ |
+ |
Similar findings have been reported in previous studies. (Moradi et al., 2018) studied the probiotic nature of Saccharomyces cerevisiae using similar screening methods and found that the strain could tolerate temperatures above the normal human body temperature. Grimoud et al., 2010 observed a high survival rate of Lactobacillus species in stimulated gastric juice and bile salt.
Stability test
Following the in-vitro tolerance testing, the viability of the presumptive probiotic strains was assessed in the whey fermented broth. The broth was treated in temperature-controlled chambers, specifically at room temperature (RT) and relative humidity (RH), at Alpha Agro R & D Laboratory. Viability tests were conducted by observing the growth of colonies on LBA and NA X-gal plates with a 10-5 times dilution. More than 108 CFU/ml (colony-forming units per milliliter) cells were found to be viable in the fermentation broth after 28 days of treatment. Coincidentally, a similar cell count of around 108 CFU/ml was reported in the study by (Drgalic et al., 2005), as reviewed by (Binda et al., 2020). To ensure the absence of cross-contamination between the presumptive probiotic cultures and any potential pathogens, a pathogenic test was conducted. This test aimed to validate the safety of the strains for probiotic applications.
Figure 11.
Colonies on a) Nutrient agar b) Nutrient agar with X-gal.
Figure 11.
Colonies on a) Nutrient agar b) Nutrient agar with X-gal.
To ensure the safety of the fermented probiotic drink, a pathogenic test was conducted targeting five major pathogens prioritized by the World Health Organization (WHO). The fermented broth that had previously passed the stability test was inoculated into specific media for each pathogen. Various indicators were analyzed according to the Indian Pharmacopeia Volume 1 guidelines. The results of the pathogenic test indicated the absence of all tested pathogens, affirming the safety of the fermented broth as a probiotic drink. A summary of the detailed pathogenic test results can be found in the table below.
Table 5.
Summary of pathogenic test of whey wine after stability test.
Table 5.
Summary of pathogenic test of whey wine after stability test.
| S.N. |
Test Pathogens |
Media Used |
Result/ Observation |
| 1. |
Staphylococcus aureus |
Casein soyabean digest broth, MSA plates |
Absence of yellow/ white colonies with yellow zones |
| 2. |
Pseudomonas aeruginosa |
Casein soyabean digest broth, Cetrimide agar |
Absence of greenish color colony. |
| 3. |
Escherichia coli |
Casein soyabean digest broth, MacConkey broth and MacConkey agar |
Absence of pink, non- mucoid colony |
| 4. |
Salmonella |
Casein soyabean digest broth, Rappaport Vassiliadis Salmonella enrichment broth And Wilson and Blair’s BBS agar. |
Absence of uniformly black colonies surrounded by a dark zone and metallic sheen |
| 5. |
Shigella |
Casein soyabean digest broth, GN broth and Xylose lysine deoxycholate medium. |
Absence of red colored translucent colony without black center. |
These findings align with previous studies that have demonstrated the potential of probiotics in combating pathogens. For instance, a study by Howarth & Wang in 2013 investigated the effect of probiotics, specifically Lactobacillus, on pathogens in live chickens. The researchers observed that the administration of probiotics over a period of 45 days resulted in a decrease in pathogens such as Salmonella and E. coli, while simultaneously increasing the number of probiotic colonies in the chickens' fecal samples. Based on this study, it can be hypothesized that the activity of the probiotic strains or their metabolites may have contributed to inhibiting the growth of these pathogens in the whey wine during storage.
Conclusion
This study demonstrates the feasibility and potential benefits of utilizing whey, a byproduct of the dairy industry, for the production of bio-ethanol and probiotic drinks. Through a series of experiments and analyses, we have shown that whey can be effectively fermented by selected bacterial strains, resulting in the production of ethanol and the preservation of viable probiotic organisms. The fermentation process revealed healthy growth of the bacterial strains in whey media, albeit with a lower ethanol concentration compared to other substrates. However, considering the abundance and renewability of whey, its utilization as a fermentation substrate offers distinct advantages over traditional food feedstock. Furthermore, the fermentation of whey resulted in a significant reduction in the organic load, indicating its potential as an environmentally friendly approach to whey management.
The probiotic strains used from the fermented whey demonstrated desirable characteristics such as tolerance to bile salt, gastric juice, high temperatures, and low pH levels. These properties make them promising candidates for probiotic applications. Moreover, the absence of major pathogens in the fermented broth confirms its safety for consumption. The distillation of ethanol from the whey wine provided insights into the various temperature conditions and their impact on the quality of the distillate. It was observed that distillation at room temperature using a vacuum resulted in a clear, high-quality product while preserving the inherent fragrance of the substrate. This method may have potential applications in specialized fermentation processes where maintaining specific flavors or aromas is desired. Overall, this study highlights the potential of whey as a valuable resource for biofuel production and the generation of probiotic drinks. By utilizing whey, we can address both the environmental challenges associated with waste management and the increasing demand for sustainable energy sources. Furthermore, the production of safe and functional probiotic drinks from whey opens up new opportunities for the development of value-added dairy products.
Future research should focus on optimizing the fermentation process to enhance ethanol yields and exploring methods to increase the lactose utilization efficiency of the bacterial strains. Additionally, further investigations into the specific probiotic properties and health benefits of the isolated strains are warranted. By continuing to explore the potential of whey and its utilization in bioprocesses, we can contribute to a more sustainable and resource-efficient future.
Author’s contributions
D.M and S.T.M. did major works including isolation and characterization of bacteria, fermentation and other tests. D.M, S.P and M.P. were major contributors in writing the manuscript. P.A and D.M designed the overall outline of the whole project. Most of the results analysis parts were performed by D.M and S.G. S.M and G.C assisted during sample collection, distillation and probiotic test of organisms.
Ethics approval and consent to participate
Not applicable.
Consent for publication
Not applicable.
Availability of data and materials
Not applicable.
Acknowledgements
The authors would like to acknowledge Central Department of Biotechnology, Tribhuvan University for providing space to perform lab works.
Competing interests
“The authors declare that they have no competing interests”.
References
- Andriani, Y.; Rochima, E.; Safitri, R.; Rahayuningsih, S.R. Characterization of Bacillus megaterium and Bacillus mycoides bacteria as probiotic bacteria in fish and shrimp feed. KnE Life Sciences 2017, 127–135. [Google Scholar] [CrossRef]
- Begley, M.; Hill, C.; Gahan, C.G. Bile salt hydrolase activity in probiotics. Applied and Environmental Microbiology 2006, 72, 1729–1738. [Google Scholar] [CrossRef] [PubMed]
- Binda, S.; Hill, C.; Johansen, E.; Obis, D.; Pot, B.; Sanders, M.E.; Tremblay, A.; Ouwehand, A.C. Criteria to qualify microorganisms as “probiotic” in foods and dietary supplements. Frontiers in Microbiology 2020, 11, 1662. [Google Scholar] [CrossRef] [PubMed]
- Black, C.; Ditsler, D.E. Dehydration of aqueous ethanol mixtures by extractive distillation. ACS Publications: 1972.
- Borriss, R.; Danchin, A.; Harwood, C.R.; Médigue, C.; Rocha, E.P.; Sekowska, A.; Vallenet, D. Bacillus subtilis, the model Gram-positive bacterium: 20 years of annotation refinement. Microbial Biotechnology 2018, 11, 3–17. [Google Scholar] [CrossRef]
- Bouknight, R.R.; Sadoff, H.L. Transport of D-and L-tryptophan in Bacillus megaterium by an inducible permease. Journal of Bacteriology 1975, 121, 65–69. [Google Scholar] [CrossRef]
- Briggs, A. The resistances of spores of the genus Bacillus to phenol, heat and radiation. Journal of Applied Bacteriology 1966, 29, 490–504. [Google Scholar] [CrossRef]
- Claassen, P.A.M.; Van Lier, J.B.; Lopez Contreras, A.M.; Van Niel, E.W.J.; Sijtsma, L.; Stams, A.J.M.; De Vries, S.S.; Weusthuis, R.A. Utilisation of biomass for the supply of energy carriers. Applied Microbiology and Biotechnology 1999, 52, 741–755. [Google Scholar] [CrossRef]
- Coté, A.; Brown, W.A.; Cameron, D.; Van Walsum, G.P. Hydrolysis of lactose in whey permeate for subsequent fermentation to ethanol. Journal of Dairy Science 2004, 87, 1608–1620. [Google Scholar] [CrossRef]
- Drgalic, I.; Tratnik, L.; Bozanic, R. Growth and survival of probiotic bacteria in reconstituted whey. Le Lait 2005, 85, 171–179. [Google Scholar] [CrossRef]
- Fang, X.; Shen, Y.; Zhao, J.; Bao, X.; Qu, Y. Status and prospect of lignocellulosic bioethanol production in China. Bioresource Technology 2010, 101, 4814–4819. [Google Scholar] [CrossRef]
- Faria-Oliveira, F.; Diniz, R.H.; Godoy-Santos, F.; Piló, F.B.; Mezadri, H.; Castro, I.M.; Brandão, R.L. The role of yeast and lactic acid bacteria in the production of fermented beverages in South America. Food Production and Industry 2015, 107–135. [Google Scholar]
- Fox, P.F.; Guinee, T.P.; Cogan, T.M.; McSweeney PLH (2017) Cheese Yield In, P.F. Fox, T.P. Guinee, T.M. Cogan, & P. L. H. McSweeney (Eds.), Fundamentals of Cheese Science (pp. 279–331). Springer US. [CrossRef]
- Grimoud, J.; Durand, H.; Courtin, C.; Monsan, P.; Ouarné, F.; Theodorou, V.; Roques, C. In vitro screening of probiotic lactic acid bacteria and prebiotic glucooligosaccharides to select effective synbiotics. Anaerobe 2010, 16, 493–500. [Google Scholar] [CrossRef] [PubMed]
- Guimarães, P.M.; Teixeira, J.A.; Domingues, L. Fermentation of lactose to bio-ethanol by yeasts as part of integrated solutions for the valorisation of cheese whey. Biotechnology Advances 2010, 28, 375–384. [Google Scholar] [CrossRef] [PubMed]
- Helm, I.; Jalukse, L.; Leito, I. A highly accurate method for determination of dissolved oxygen: Gravimetric Winkler method. Analytica Chimica Acta 2012, 741, 21–31. [Google Scholar] [CrossRef] [PubMed]
- Howarth, G.S.; Wang, H. Role of endogenous microbiota, probiotics and their biological products in human health. Nutrients 2013, 5, 58–81. [Google Scholar] [CrossRef]
- Iglesias, A.; Pascoal, A.; Choupina, A.B.; Carvalho, C.A.; Feás, X.; Estevinho, L.M. Developments in the Fermentation Process and Quality Improvement Strategies for Mead Production. Molecules 2014, 19, 12577–12590. [Google Scholar] [CrossRef]
- Kamel, Z.; Mohamed, N.M.; Farahat, M.G. Optimization of Culture Conditions for Production of B-Galactosidase by Bacillus Megaterium NM56 Isolated from Raw Milk. RESEARCH JOURNAL OF PHARMACEUTICAL BIOLOGICAL AND CHEMICAL SCIENCES 2016, 7, 366–376. [Google Scholar]
- Kosikowski, F.V.; Wzorek, W. Whey wine from concentrates of reconstituted acid whey powder. Journal of Dairy Science 1977, 60, 1982–1986. [Google Scholar] [CrossRef]
- Kumar, S.; Singh, N.; Prasad, R. Anhydrous ethanol: A renewable source of energy. Renewable and Sustainable Energy Reviews 2010, 14, 1830–1844. [Google Scholar] [CrossRef]
- Ladisch, M.R.; Dyck, K. Dehydration of ethanol: New approach gives positive energy balance. Science 1979, 205, 898–900. [Google Scholar] [CrossRef]
- Lappa, I.K.; Papadaki, A.; Kachrimanidou, V.; Terpou, A.; Koulougliotis, D.; Eriotou, E.; Kopsahelis, N. Cheese Whey Processing: Integrated Biorefinery Concepts and Emerging Food Applications. Foods 2019, 8, 347. [Google Scholar] [CrossRef] [PubMed]
- Leonardi, M.; Gerbault, P.; Thomas, M.G.; Burger, J. The evolution of lactase persistence in Europe. A synthesis of archaeological and genetic evidence. International Dairy Journal 2012, 22, 88–97. [Google Scholar] [CrossRef]
- Licht, F.O. (2003). World ethanol markets: The outlook to 2012: An FO Licht special study.
- Luongo, V.; Policastro, G.; Ghimire, A.; Pirozzi, F.; Fabbricino, M. Repeated-batch fermentation of cheese whey for semi-continuous lactic acid production using mixed cultures at uncontrolled pH. Sustainability 2019, 11, 3330. [Google Scholar] [CrossRef]
- Macwan, S.R.; Dabhi, B.K.; Parmar, S.C.; Aparnathi, K.D. Whey and its utilization. International Journal of Current Microbiology and Applied Sciences 2016, 5, 134–155. [Google Scholar] [CrossRef]
- Maicas, S. (2020). The role of yeasts in fermentation processes. In Microorganisms (Vol. 8, Issue 8, p. 1142). MDPI.
- Marteau, P.R.; Vrese, M. de, Cellier, C.J.; Schrezenmeir, J. Protection from gastrointestinal diseases with the use of probiotics. The American Journal of Clinical Nutrition 2001, 73, 430s–436s. [Google Scholar] [CrossRef]
- McNulty, C.A.; Wise, R. Gastric microflora. British Medical Journal (Clinical Research Ed.) 1985, 291, 367. [Google Scholar] [CrossRef] [PubMed]
- Mondiale, B. (2008). World development report 2008: Agriculture for development.
- Moradi, R.; Nosrati, R.; Zare, H.; Tahmasebi, T.; Saderi, H.; Owlia, P. Screening and characterization of in-vitro probiotic criteria of Saccharomyces and Kluyveromyces strains. Iranian Journal of Microbiology 2018, 10, 123. [Google Scholar]
- Natarajan, J.; Christobell, C.; Kumar, D.M.; Balakumaran, M.D.; Kumar, M.R.; Kalaichelvan, P.T. Isolation and Characterization of $-Galactosidase Producing Bacillus sp. From Dairy Effluent. World Applied Sciences Journal 2012, 17, 1466–1474. [Google Scholar]
- OECD. (2020). OECD-FAO Agricultural Outlook 2020-2029, Organisation for Economic Co-operation and Development, 2020. Available online: https://www.oecd-ilibrary.org/agriculture-and-food/oecd-fao-agricultural-outlook-2020-2029_1112c23b-en.
- Panesar, P.S.; Kumari, S.; Panesar, R. (2010). Potential applications of immobilized β-galactosidase in food processing industries. Enzyme Research.
- Papademas, P.; Kotsaki, P. (2020). Technological Utilization of Whey towards Sustainable Exploitation.
- Parapouli, M.; Vasileiadis, A.; Afendra, A.-S.; Hatziloukas, E. Saccharomyces cerevisiae and its industrial applications. AIMS Microbiology 2020, 6, 1. [Google Scholar] [CrossRef]
- Pendón, M.D.; Madeira, J.V.; Romanin, D.E.; Rumbo, M.; Gombert, A.K.; Garrote, G.L. A biorefinery concept for the production of fuel ethanol, probiotic yeast, and whey protein from a by-product of the cheese industry. Applied Microbiology and Biotechnology 2021, 105, 3859–3871. [Google Scholar] [CrossRef]
- Percival, G.C.; Chamundeeswari, M.; Lovlyna, R.F.; Seethalakshmi, R.; Sreekumar, G. (2019). Production and partial purification of β-galactosidase enzyme from probiotic Bacillus subtilis SK09.
- Saqib, A.; Whitney, P. Differential behaviour of the dinitrosalicylic acid (DNS) reagent towards mono- and di-saccharide sugars. Biomass and Bioenergy 2011, 35. [Google Scholar] [CrossRef]
- Saqib, S.; Akram, A.; Halim, S.A.; Tassaduq, R. Sources of β-galactosidase and its applications in food industry. 3 Biotech 2017, 7, 79. [Google Scholar] [CrossRef] [PubMed]
- Scholle, M.D.; White, C.A.; Kunnimalaiyaan, M.; Vary, P.S. Sequencing and characterization of pBM400 from Bacillus megaterium QM B1551. Applied and Environmental Microbiology 2003, 69, 6888–6898. [Google Scholar] [CrossRef] [PubMed]
- Seo, H.-B.; Kim, H.-J.; Lee, O.-K.; Ha, J.-H.; Lee, H.-Y.; Jung, K.-H. Measurement of ethanol concentration using solvent extraction and dichromate oxidation and its application to bioethanol production process. Journal of Industrial Microbiology and Biotechnology 2009, 36, 285–292. [Google Scholar] [CrossRef]
- Seo, H.-B.; Kim, H.-J.; Lee, O.-K.; Ha, J.-H.; Lee, H.-Y.; Jung, K.-H. Measurement of ethanol concentration using solvent extraction and dichromate oxidation and its application to bioethanol production process. Journal of Industrial Microbiology and Biotechnology 2009, 36, 285–292. [Google Scholar] [CrossRef]
- Shaw, G.-C.; Chiou, C.-Y.; Chou, Y.-H.; Li, J.-M. MbgA-dependent lactose utilization by Bacillus megaterium. Current Microbiology 2002, 44, 102–105. [Google Scholar] [CrossRef]
- Smithers, G.W. Whey and whey proteins—From ‘gutter-to-gold. ’ International Dairy Journal 2008, 18, 695–704. [Google Scholar] [CrossRef]
- Somoza, V. Five years of research on health risks and benefits of Maillard reaction products: An update. Molecular Nutrition & Food Research 2005, 49, 663–672. [Google Scholar]
- Teixeira, J.A.; Domingues, L. Fermentation of deproteinized cheese whey powder solutions to ethanol by engineered Saccharomyces cerevisiae. J Ind Microbiol Biotechnol 2010, 37, 973–982. [Google Scholar]
- Waterborg JH (2009) The Lowry Method for Protein Quantitation In, J.M. Waterborg JH (2009) The Lowry Method for Protein Quantitation In, J.M. Walker (Ed.), The Protein Protocols Handbook (pp. 7–10). Humana Press. [CrossRef]
- Williams, B.S.; Isokpehi, R.D.; Mbah, A.N.; Hollman, A.L.; Bernard, C.O.; Simmons, S.S.; Ayensu, W.K.; Garner, B.L. Functional Annotation Analytics of Bacillus Genomes Reveals Stress Responsive Acetate Utilization and Sulfate Uptake in the Biotechnologically Relevant Bacillus megaterium. Bioinformatics and Biology Insights 2012, 6, BBIS7977. [Google Scholar] [CrossRef]
- Wong, N.P.; LaCroix, D.E.; McDonough, F.E. Minerals in whey and whey fractions. Journal of Dairy Science 1978, 61, 1700–1703. [Google Scholar] [CrossRef] [PubMed]
- Zotta, T.; Solieri, L.; Iacumin, L.; Picozzi, C.; Gullo, M. Valorization of cheese whey using microbial fermentations. Applied Microbiology and Biotechnology 2020, 104, 2749–2764. [Google Scholar] [CrossRef] [PubMed]
|
Disclaimer/Publisher’s Note: The statements, opinions and data contained in all publications are solely those of the individual author(s) and contributor(s) and not of MDPI and/or the editor(s). MDPI and/or the editor(s) disclaim responsibility for any injury to people or property resulting from any ideas, methods, instructions or products referred to in the content. |
© 2023 by the authors. Licensee MDPI, Basel, Switzerland. This article is an open access article distributed under the terms and conditions of the Creative Commons Attribution (CC BY) license (https://creativecommons.org/licenses/by/4.0/).